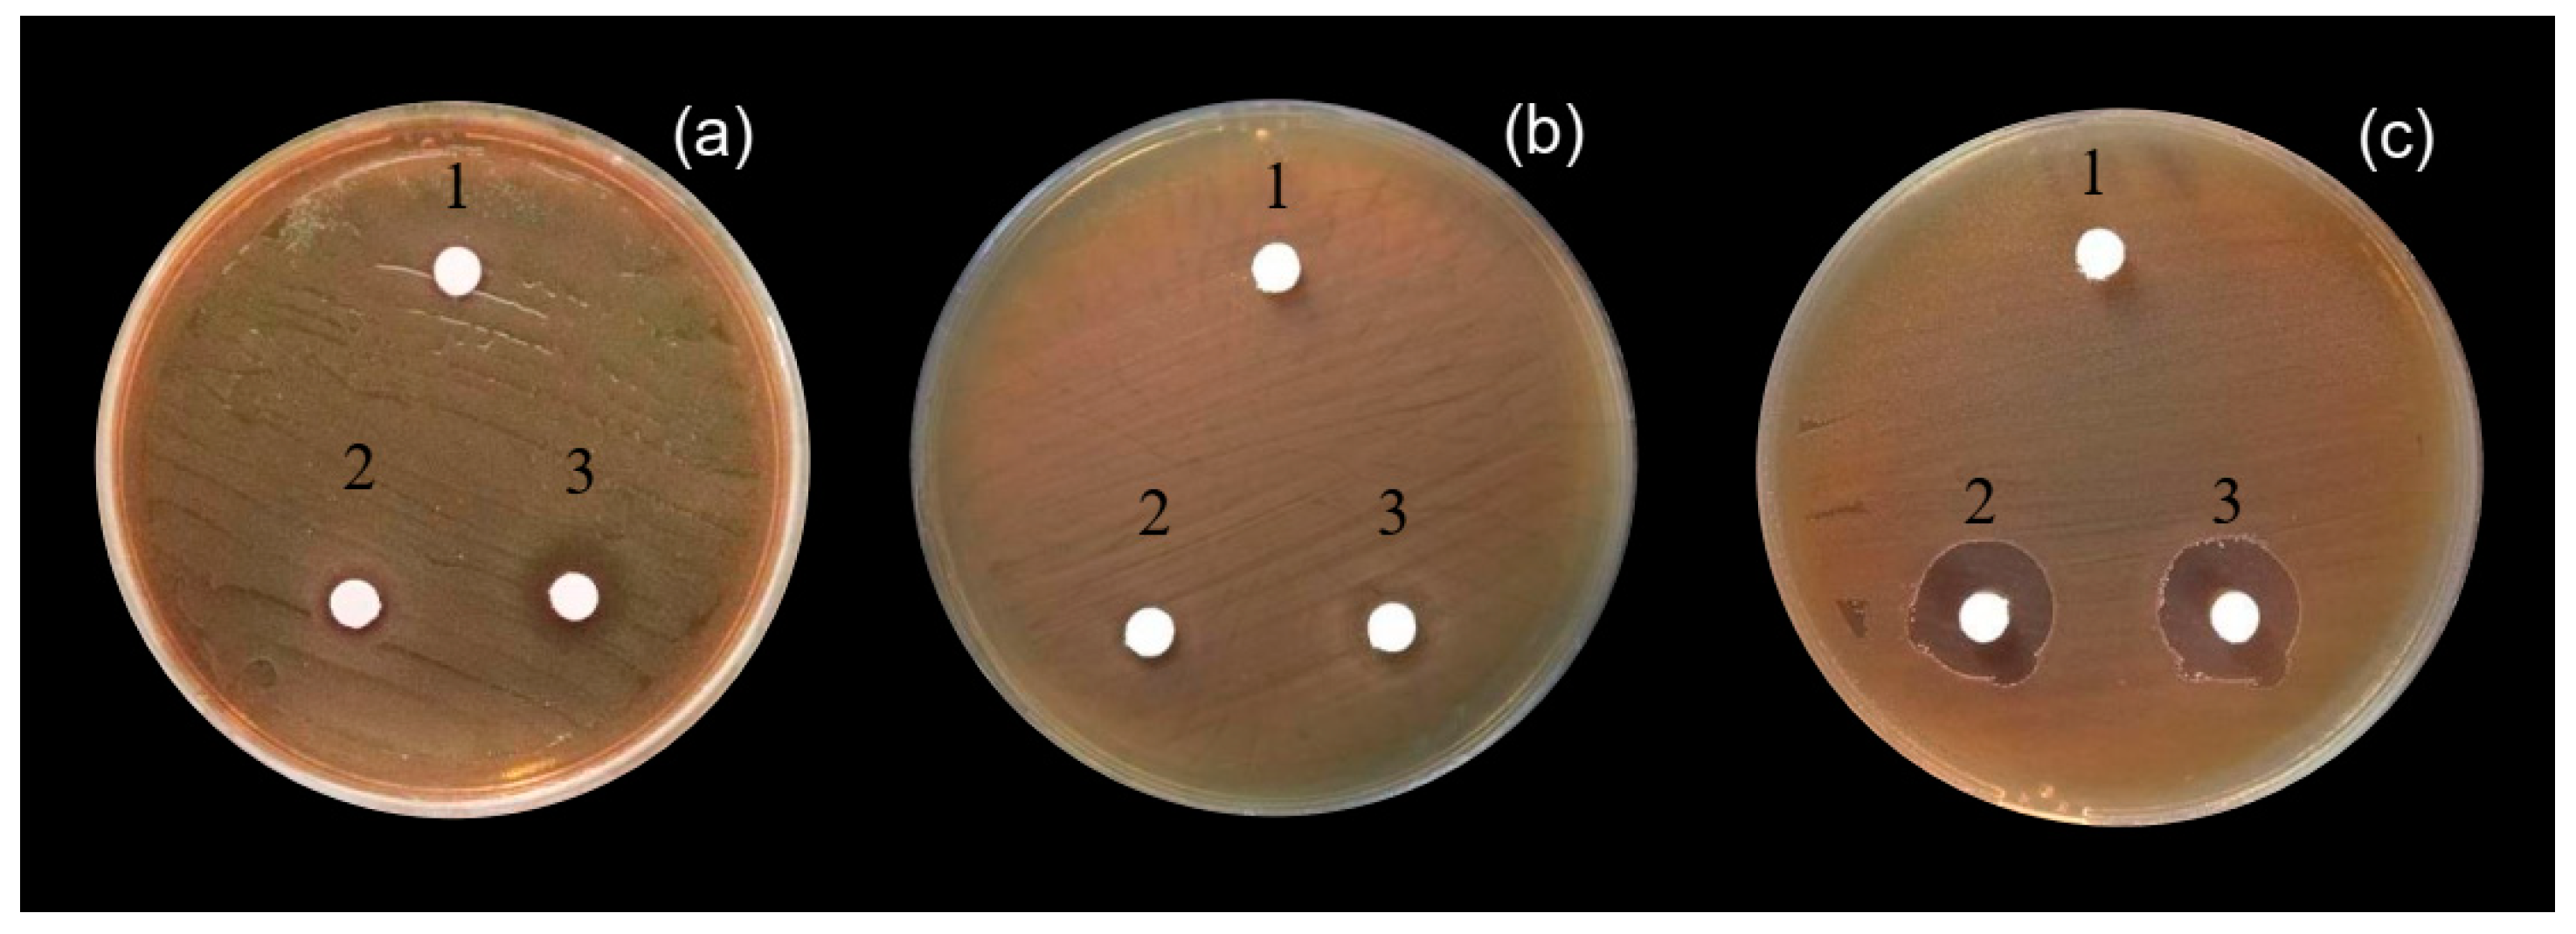
Fermentation 05 00032 g004

Simultaneous Bioconversion of Gelatinized Starchy Waste from the Rice Noodle Manufacturing Process to Lactic Acid and Maltose-Forming α-Amylase by Lactobacillus plantarum S21, Using a Low-Cost Medium
Abstract
:1. Introduction
2. Materials and Methods
2.1. Microorganisms and Culture Conditions
2.2. Raw Materials and Culture Media
2.3. Screening of Nitrogen Sources for Lactic Acid Production
2.4. Screening of Factors Influencing Lactic Acid Fermentation, using a Plackett–Burman Design
2.5. Statistical Medium Optimization of Lactic Acid Fermentation by L. plantarum S21
2.6. Effect of the Mineral Component Eradication from the Optimized Medium on Lactic Acid Production
2.7. Antimicrobial Activity of Crude Lactic Acid Produced by L. plantarum S21
2.8. Lactic Acid Production in a 10 L Jar Fermenter
2.9. Separation of Maltose-Forming α-Amylase
2.10. Lactic Acid Determination and Amylase Activity Assay
3. Results
3.1. Screening and Selection of Nitrogen Sources
3.2. Screening of Significant Influential Medium Components, by the Plackett–Burman Design
3.3. Quantitative Optimization of Significant Components by CCD
3.4. Comparison of Lactic Acid Fermentation on OM and OM-Mi in a 1 L Fermenter
3.5. Antimicrobial Activity of Crude Lactic Acid Produced by L. plantarum S21
3.6. Trial Experiments for the Separation of Maltose-Forming α-Amylase from CFCS
4. Discussion
5. Conclusions
Author Contributions
Funding
Acknowledgments
Conflicts of Interest
References
- Adil, S.; Banday, T.; Bhat, G.A.; Mir, M.S.; Rehman, M. Effect of dietary supplementation of organic acids on performance, intestinal histomorphology, and serum biochemistry of broiler chicken. Vet. Med. Int. 2010, 2010, 479485. [Google Scholar] [CrossRef] [PubMed]
- Özogul, F.; Hamed, I. The importance of lactic acid bacteria for the prevention of bacterial growth and their biogenic amines formation: A review. Crit. Rev. Food Sci. Nutr. 2018, 58, 1660–1670. [Google Scholar] [CrossRef] [PubMed]
- Roth, F.; Kirchgessner, M. Organic acids as feed additives for young pigs: Nutritional and gastrointestinal effects. J. Anim. Feed Sci. 1998, 7, 25–33. [Google Scholar] [CrossRef] [Green Version]
- Rychen, G.; Aquilina, G.; Azimonti, G.; Bampidis, V.; Bastos, M.d.L.; Bories, G.; Chesson, A.; Cocconcelli, P.S.; Flachowsky, G.; Kolar, B.; et al. Safety of lactic acid and calcium lactate when used as technological additives for all animal species. EFSA J. 2017, 15, 4938. [Google Scholar] [CrossRef]
- Wang, Y.; Tashiro, Y.; Sonomoto, K. Fermentative production of lactic acid from renewable materials: Recent achievements, prospects, and limits. J. Biosci. Bioeng. 2015, 119, 10–18. [Google Scholar] [CrossRef]
- Ghaffar, T.; Irshad, M.; Anwar, Z.; Aqil, T.; Zulifqar, Z.; Tariq, A.; Kamran, M.; Ehsan, N.; Mehmood, S. Recent trends in lactic acid biotechnology: A brief review on production to purification. J. Radiat. Res. Appl. Sci. 2014, 7, 222–229. [Google Scholar] [CrossRef]
- Abdel-Rahman, M.A.; Tashiro, Y.; Sonomoto, K. Recent advances in lactic acid production by microbial fermentation processes. Biotechnol. Adv. 2013, 31, 877–902. [Google Scholar] [CrossRef] [PubMed]
- Bernardo, M.P.; Coelho, L.F.; Sass, D.C.; Contiero, J. l-(+)-lactic acid production by Lactobacillus rhamnosus B103 from dairy industry waste. Braz. J. Microbiol. 2016, 47, 640–646. [Google Scholar] [CrossRef]
- Thakur, A.; Panesar, P.S.; Saini, M.S. l (+)-lactic acid production by immobilized Lactobacillus casei using low cost agro-industrial waste as carbon and nitrogen sources. Waste Biomass Valor. 2017, 1–11. [Google Scholar] [CrossRef]
- Brock, S.; Kuenz, A.; Prüße, U. Impact of hydrolysis methods on the utilization of agricultural residues as nutrient source for d-lactic acid production by Sporolactobacillus inulinus. Fermentation 2019, 5, 12. [Google Scholar] [CrossRef]
- Palmerín-Carreño, D.M.; Hernández-Orihuela, A.L.; Martínez-Antonio, A. Production of D-lactate from avocado seed hydrolysates by metabolically engineered Escherichia coli JU15. Fermentation 2019, 5, 26. [Google Scholar] [CrossRef]
- Komesu, A.; de Oliveira, J.A.R.; da Silva Martins, L.H.; Maciel, M.R.W.; Maciel Filho, R. Lactic acid production to purification: A review. Bioresources 2017, 12, 4364–4383. [Google Scholar] [CrossRef]
- Kanpiengjai, A.; Lumyong, S.; Pathom-aree, W.; Khanongnuch, C. Starchy effluent from rice noodle manufacturing process as feasible substrate for direct lactic acid production by Lactobacillus plantarum S21. J. Korean Soc. Appl. Biol. Chem. 2014, 57, 217–220. [Google Scholar] [CrossRef]
- Altaf, M.; Naveena, B.J.; Reddy, G. Use of inexpensive nitrogen sources and starch for l(+) lactic acid production in anaerobic submerged fermentation. Bioresour. Technol. 2007, 98, 498–503. [Google Scholar] [CrossRef]
- Yousuf, A.; Bastidas-Oyanedel, J.R.; Schmidt, J.E. Effect of total solid content and pretreatment on the production of lactic acid from mixed culture dark fermentation of food waste. Waste Manag. 2018, 77, 516–521. [Google Scholar] [CrossRef]
- Tang, J.; Wang, X.; Hu, Y.; Zhang, Y.; Li, Y. Lactic acid fermentation from food waste with indigenous microbiota: Effects of pH, temperature and high OLR. Waste Manag. 2016, 52, 278–285. [Google Scholar] [CrossRef]
- Kona, R.; Qureshi, N.; Pai, J. Production of glucose oxidase using Aspergillus niger and corn steep liquor. Bioresour. Technol. 2001, 78, 123–126. [Google Scholar] [CrossRef]
- De la Torre, I.; Ladero, M.; Santos, V. Production of D-lactic acid by Lactobacillus delbrueckii ssp. delbrueckii from orange peel waste: Techno-economical assessment of nitrogen sources. Appl. Microbiol. Biotechnol. 2018, 102, 10511–10521. [Google Scholar] [CrossRef]
- Panesar, P.S.; Kaur, S. Bioutilisation of agro-industrial waste for lactic acid production. Int. J. Food Sci. Tech. 2015, 50, 2143–2151. [Google Scholar] [CrossRef]
- Russo, P.; Fares, C.; Longo, A.; Spano, G.; Capozzi, V. Lactobacillus plantarum with broad antifungal activity as a protective starter culture for bread production. Foods 2017, 6, 110. [Google Scholar] [CrossRef]
- Huang, W.-C.; Wei, C.-C.; Huang, C.-C.; Chen, W.-L.; Huang, H.-Y. The beneficial effects of Lactobacillus plantarum PS128 on high-intensity, exercise-induced oxidative stress, inflammation, and performance in triathletes. Nutrients 2019, 11, 353. [Google Scholar] [CrossRef]
- Berbegal, C.; Garofalo, C.; Russo, P.; Pati, S.; Capozzi, V.; Spano, G. Use of autochthonous yeasts and bacteria in order to control Brettanomyces bruxellensis in wine. Fermentation 2017, 3, 65. [Google Scholar] [CrossRef]
- Capozzi, V.; Russo, P.; Fragasso, M.; De Vita, P.; Fiocco, D.; Spano, G. Biotechnology and pasta-making: Lactic acid bacteria as a new driver of innovation. Front. Microbiol. 2012, 3, 94. [Google Scholar] [CrossRef]
- Wee, Y.J.; Kim, J.N.; Ryu, H.W. Biotechnological production of lactic acid and its recent applications. Food Technol. Biotechnol. 2006, 44, 163–172. [Google Scholar]
- Kanpiengjai, A.; Rieantrakoonchai, W.; Pratanaphon, R.; Pathom-aree, W.; Lumyong, S.; Khanongnuch, C. High efficacy bioconversion of starch to lactic acid using an amylolytic lactic acid bacterium isolated from Thai indigenous fermented rice noodles. Food Sci. Biotechnol. 2014, 23, 1541–1550. [Google Scholar] [CrossRef]
- Kanpiengjai, A.; Lumyong, S.; Nguyen, T.H.; Haltrich, D.; Khanongnuch, C. Characterization of a maltose-forming α-amylase from an amylolytic lactic acid bacterium Lactobacillus plantarum S21. J. Mol. Catal. B Enzym. 2015, 120, 1–8. [Google Scholar] [CrossRef]
- Dubois, M.; Gilles, K.A.; Hamilton, J.K.; Rebers, P.A.; Smith, F. Colorimetric method for determination of sugars and related substances. Anal. Chem. 1956, 28, 350–356. [Google Scholar] [CrossRef]
- Miller, G.L. Use of dinitrosalicylic acid reagent for determination of reducing sugar. Anal. Chem. 1959, 31, 426–428. [Google Scholar] [CrossRef]
- Altaf, M.; Naveena, B.J.; Venkateshwar, M.; Kumar, E.V.; Reddy, G. Single step fermentation of starch to l(+) lactic acid by Lactobacillus amylophilus GV6 in SSF using inexpensive nitrogen sources to replace peptone and yeast extract—Optimization by RSM. Process Biochem. 2006, 41, 465–472. [Google Scholar] [CrossRef]
- Chiani, M.; Akbarzadeh, A.; Farhangi, A.; Mehrabi, M. Production of desferrioxamine B (Desferal) using corn steep liquor in Streptomyces pilosus. Pak. J. Biol. Sci. 2010, 13, 1151–1155. [Google Scholar] [CrossRef]
- Yu, L.; Lei, T.; Ren, X.; Pei, X.; Feng, Y. Response surface optimization of l-(+)-lactic acid production using corn steep liquor as an alternative nitrogen source by Lactobacillus rhamnosus CGMCC 1466. Biochem. Eng. J. 2008, 39, 496–502. [Google Scholar] [CrossRef]
- Hull, S.R.; Yang, B.Y.; Venzke, D.; Kulhavy, K.; Montgomery, R. Composition of corn steep water during steeping. J. Agric. Food Chem. 1996, 44, 1857–1863. [Google Scholar] [CrossRef]
- Senz, M.; Keil, C.; Schmacht, M.; Palinski, S.; Cämmerer, B.; Hageböck, M. Influence of media heat sterilization process on growth performance of representative strains of the genus Lactobacillus. Fermentation 2019, 5, 20. [Google Scholar] [CrossRef]
- Avci, A.; Saha, B.C.; Dien, B.S.; Kennedy, G.J.; Cotta, M.A. Response surface optimization of corn stover pretreatment using dilute phosphoric acid for enzymatic hydrolysis and ethanol production. Bioresour. Technol. 2013, 130, 603–612. [Google Scholar] [CrossRef]
- Cingadi, S.; Srikanth, K.; Arun, E.; Sivaprakasam, S. Statistical optimization of cassava fibrous waste hydrolysis by response surface methodology and use of hydrolysate based media for the production of optically pure d-lactic acid. Biochem. Eng. J. 2015, 102, 82–90. [Google Scholar] [CrossRef]
- Zhang, J.; Dong, Y.C.; Fan, L.L.; Jiao, Z.H.; Chen, Q.H. Optimization of culture medium compositions for gellan gum production by a halobacterium Sphingomonas paucimobilis. Carbohydr. Polym. 2015, 115, 694–700. [Google Scholar] [CrossRef]
- Mor-Mur, M.; Yuste, J. Emerging bacterial pathogens in meat and poultry: An overview. Food Bioprocess Technol. 2010, 3, 24. [Google Scholar] [CrossRef]
- Gupta, A.; Tiwari, S.K. Plantaricin LD1: A bacteriocin produced by food isolate of Lactobacillus plantarum LD1. Appl. Biochem. Biotechnol. 2014, 172, 3354–3362. [Google Scholar] [CrossRef]
- Holo, H.; Jeknic, Z.; Daeschel, M.; Stevanovic, S.; Nes, I.F. Plantaricin W from Lactobacillus plantarum belongs to a new family of two-peptide lantibiotics. Microbiology 2001, 147, 643–651. [Google Scholar] [CrossRef]
- Khan, S.H.; Iqbal, J. Recent advances in the role of organic acids in poultry nutrition. J. Appl. Anim. Res. 2016, 44, 359–369. [Google Scholar] [CrossRef]
- Mohammad, A.W.; Ng, C.Y.; Lim, Y.P.; Ng, G.H. Ultrafiltration in food processing industry: Review on application, membrane fouling, and fouling control. Food Bioprocess Technol. 2012, 5, 1143–1156. [Google Scholar] [CrossRef]

| Variable code | Medium components | Unit | Range and levels | ||||
|---|---|---|---|---|---|---|---|
| −1.682 | −1 | 0 | +1 | +1.682 | |||
| X1 | GSW | g/L | 72.50 | 83.12 | 108.75 | 134.38 | 145.00 |
| X2 | CSL | g/L | 50.00 | 86.60 | 175.00 | 263.39 | 300.00 |
| Variables | Code | Low level (−1) | High level (+1) | Coefficient | p-value |
|---|---|---|---|---|---|
| Model | - | - | - | 0.0897 | 0.0011 a |
| GSW | X1 | 1 | 15 | 0.7344 | <0.0001 a |
| CSL | X2 | 1 | 10 | 0.1875 | 0.0153 a |
| K2HPO4 | X3 | 1 | 5 | −0.2079 | 0.0901 |
| CH3COONa∙3H2O | X4 | 1 | 10 | −0.0627 | 0.1919 |
| (NH4)2HC6H5O7 | X5 | 0.5 | 3.5 | −0.1705 | 0.2259 |
| MgSO4∙7H2O | X6 | 0.05 | 0.35 | 2.3500 | 0.1273 |
| MnSO4∙7H2O | X7 | 0.05 | 0.35 | −2.1277 | 0.1543 |
| Tween80 | X8 | 0.1 | 2 | −0.0271 | 0.8878 |
| R-square (R2) | 0.9969 | ||||
| Adjust R-square | 0.9888 | ||||
| Run | Coded values and actual values | Lactic acid (g/L) | ||
|---|---|---|---|---|
| GSW (g/L) | CSL (g/L) | Experimental | Predicted | |
| 1 | −1 (83.12) | −1 (86.61) | 57.15 | 56.44 |
| 2 | 1 (134.38) | −1 (86.61) | 75.41 | 81.62 |
| 3 | −1 (83.12) | +1 (263.39) | 59.03 | 57.44 |
| 4 | 1 (134.38) | +1 (263.39) | 86.80 | 92.14 |
| 5 | −1.682 (72.50) | 0 (175.00) | 63.23 | 75.28 |
| 6 | +1.682 (145.00) | 0 (175.00) | 115.38 | 105.22 |
| 7 | 0 (108.75) | −1.682 (50.00) | 55.67 | 72.28 |
| 8 | 0 (108.75) | +1.682 (300.00) | 62.56 | 78.04 |
| 9 | 0 (108.75) | 0 (175.00) | 90.33 | 93.50 |
| 10 | 0 (108.75) | 0 (175.00) | 91.42 | 93.50 |
| 11 | 0 (108.75) | 0 (175.00) | 95.26 | 93.50 |
| 12 | 0 (108.75) | 0 (175.00) | 98.00 | 93.50 |
| 13 | 0 (108.75) | 0 (175.00) | 92.49 | 93.50 |
| Source | Coefficient estimate | SS | df | MS | F-value | p-value |
|---|---|---|---|---|---|---|
| (Prob > F) | ||||||
| Intercept/Model | 93.50 | 4229.12 | 5 | 845.82 | 33.09 | <0.0001 |
| X1: GSW | 14.97 | 1793.98 | 1 | 1793.98 | 70.91 | <0.0001 |
| X2: CSL | 2.88 | 66.24 | 1 | 66.24 | 2.59 | 0.1515 |
| X1X2 | 2.38 | 22.63 | 1 | 22.63 | 0.89 | 0.3781 |
| X12 | −3.25 | 73.52 | 1 | 73.52 | 2.88 | 0.1337 |
| X22 | −18.34 | 2341.07 | 1 | 2341.07 | 91.59 | <0.0001 |
| Residual | 178.92 | 7 | 25.56 | |||
| Lack of fit | 140.16 | 3 | 46.72 | 4.82 | 0.0814 | |
| Pure error | 38.76 | 4 | 9.69 | |||
| R2 = 0.9594; adjusted R2 = 0.9304; CV = 6.30% | ||||||
| Volume (mL) | Amylase (U/mL) | Total amylase (U) | Recovery of amylase (%) | Lactic acid (g/L) | Total lactic acid (g) | Recovery of lactic acid (%) | |
|---|---|---|---|---|---|---|---|
| Initial CFCS | 7000 | 7.02 | 49,140 | 100.0 | 84.9 | 594,300 | 100.0 |
| Retained CFCS | 300 | 157.81 | 47,343 | 96.3 | 83.1 | 24,930 | 4.2 |
| Filtrated supernatant | 6600 | 0 | 0 | 0 | 83.2 | 549,120 | 92.4 |
© 2019 by the authors. Licensee MDPI, Basel, Switzerland. This article is an open access article distributed under the terms and conditions of the Creative Commons Attribution (CC BY) license (http://creativecommons.org/licenses/by/4.0/).
Share and Cite
Unban, K.; Kanpiengjai, A.; Khatthongngam, N.; Saenjum, C.; Khanongnuch, C. Simultaneous Bioconversion of Gelatinized Starchy Waste from the Rice Noodle Manufacturing Process to Lactic Acid and Maltose-Forming α-Amylase by Lactobacillus plantarum S21, Using a Low-Cost Medium. Fermentation 2019, 5, 32. https://doi.org/10.3390/fermentation5020032
Unban K, Kanpiengjai A, Khatthongngam N, Saenjum C, Khanongnuch C. Simultaneous Bioconversion of Gelatinized Starchy Waste from the Rice Noodle Manufacturing Process to Lactic Acid and Maltose-Forming α-Amylase by Lactobacillus plantarum S21, Using a Low-Cost Medium. Fermentation. 2019; 5(2):32. https://doi.org/10.3390/fermentation5020032
Chicago/Turabian StyleUnban, Kridsada, Apinun Kanpiengjai, Nuttapong Khatthongngam, Chalermpong Saenjum, and Chartchai Khanongnuch. 2019. "Simultaneous Bioconversion of Gelatinized Starchy Waste from the Rice Noodle Manufacturing Process to Lactic Acid and Maltose-Forming α-Amylase by Lactobacillus plantarum S21, Using a Low-Cost Medium" Fermentation 5, no. 2: 32. https://doi.org/10.3390/fermentation5020032






